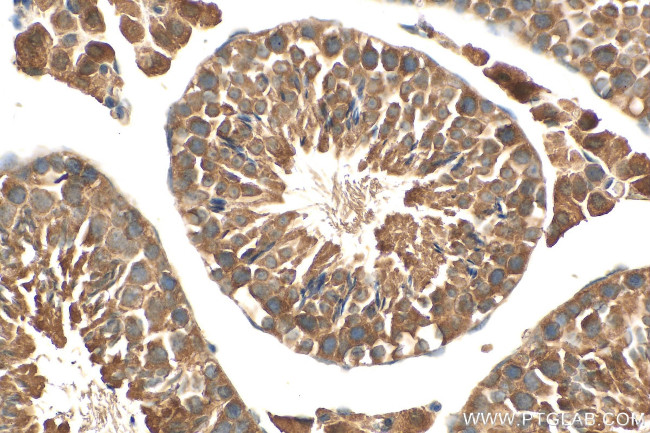
RIMKLB Antibody in Immunohistochemistry (Paraffin) (IHC (P))

Search
Proteintech
RIMKLB Polyclonal Antibody
{{$productOrderCtrl.translations['antibody.pdp.commerceCard.promotion.promotions']}}
{{$productOrderCtrl.translations['antibody.pdp.commerceCard.promotion.viewpromo']}}
{{$productOrderCtrl.translations['antibody.pdp.commerceCard.promotion.promocode']}}: {{promo.promoCode}} {{promo.promoTitle}} {{promo.promoDescription}}. {{$productOrderCtrl.translations['antibody.pdp.commerceCard.promotion.learnmore']}}
产品信息
26111-1-AP
种属反应
宿主/亚型
分类
类型
抗原
偶联物
形式
浓度
规格
纯化类型
保存液
内含物
保存条件
运输条件
产品详细信息
Immunogen sequence: MCSSVAAKL WFLTDRRIRE DYPQKEILRA LKAKCCEEEL DFRAVVMDEV VLTIEQGNLG LRINGELITA YPQVVVVRVP TPWVQSDSDI TVLRHLEKMG CRLMNRPQAI LNCVNKFWTF QELAGHGVPL PDTFSYGGHE NFAKMIDEAE VLEFPMVVKN TRGHRGKAVF LARDKHHLAD LSHLIRHEAP YLFQKYVKES HGRDVRVIVV GGRVVGTMLR CSTDGRMQSN CSLGGVGMMC SLSEQGKQLA IQVSNILGMD VCGIDLLMKD DGSFCVCEAN ANPFQEPKKQ IQTNKKIPRE KTFLLPPS (1-307 aa encoded by BC033793)
靶标信息
Catalyzes the synthesis of beta-citryl-L-glutamate and N-acetyl-L-aspartyl-L-glutamate. Beta-citryl-L-glutamate is synthesized more efficiently than N-acetyl-L-aspartyl-L-glutamate.
仅用于科研。不用于诊断过程。未经明确授权不得转售。
生物信息学
蛋白别名: beta-citryl-glutamate synthase B; Beta-citrylglutamate synthase B; family with sequence similarity 80, member B; N-acetyl-aspartyl-glutamate synthetase B; N-acetyl-aspartylglutamate synthetase B; N-acetylaspartyl-glutamate synthetase B; NAAG synthetase B; Ribosomal protein S6 modification-like protein B; unnamed protein product
基因别名: 4931417E21Rik; 4933426K21Rik; AA097693; AI325948; AU015629; FAM80B; KIAA1238; NAAGS; NAAGS-I; RIMKLB
UniProt ID: (Human) Q9ULI2, (Mouse) Q80WS1
Entrez Gene ID: (Human) 57494, (Mouse) 108653